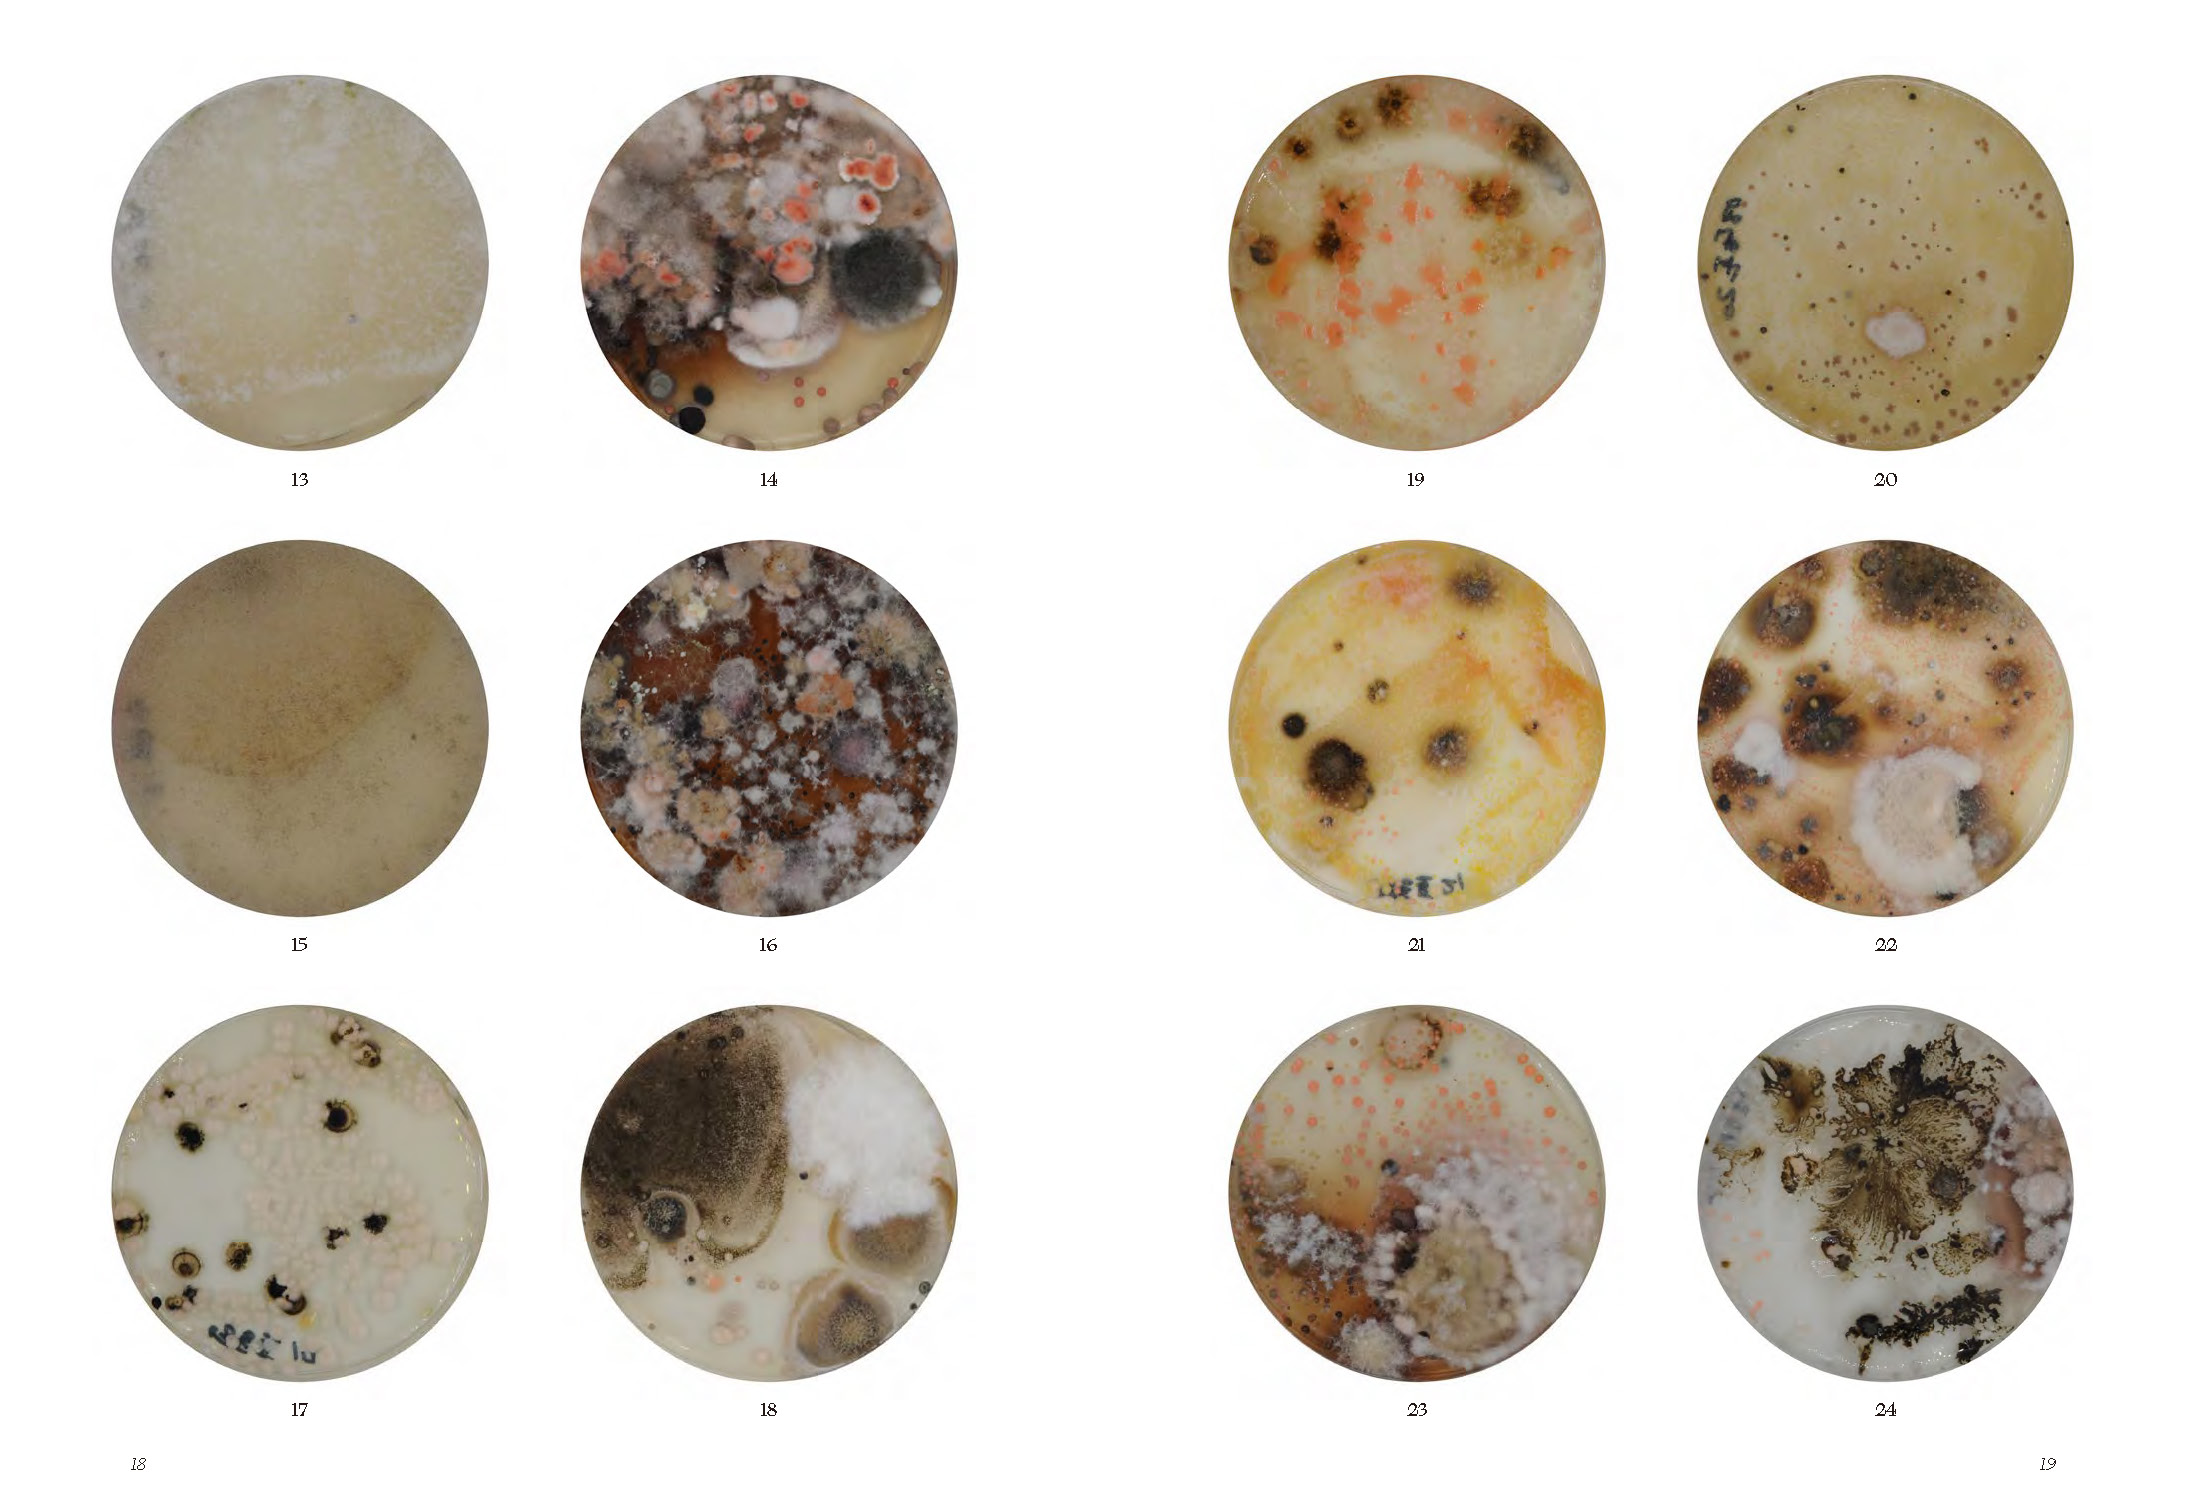
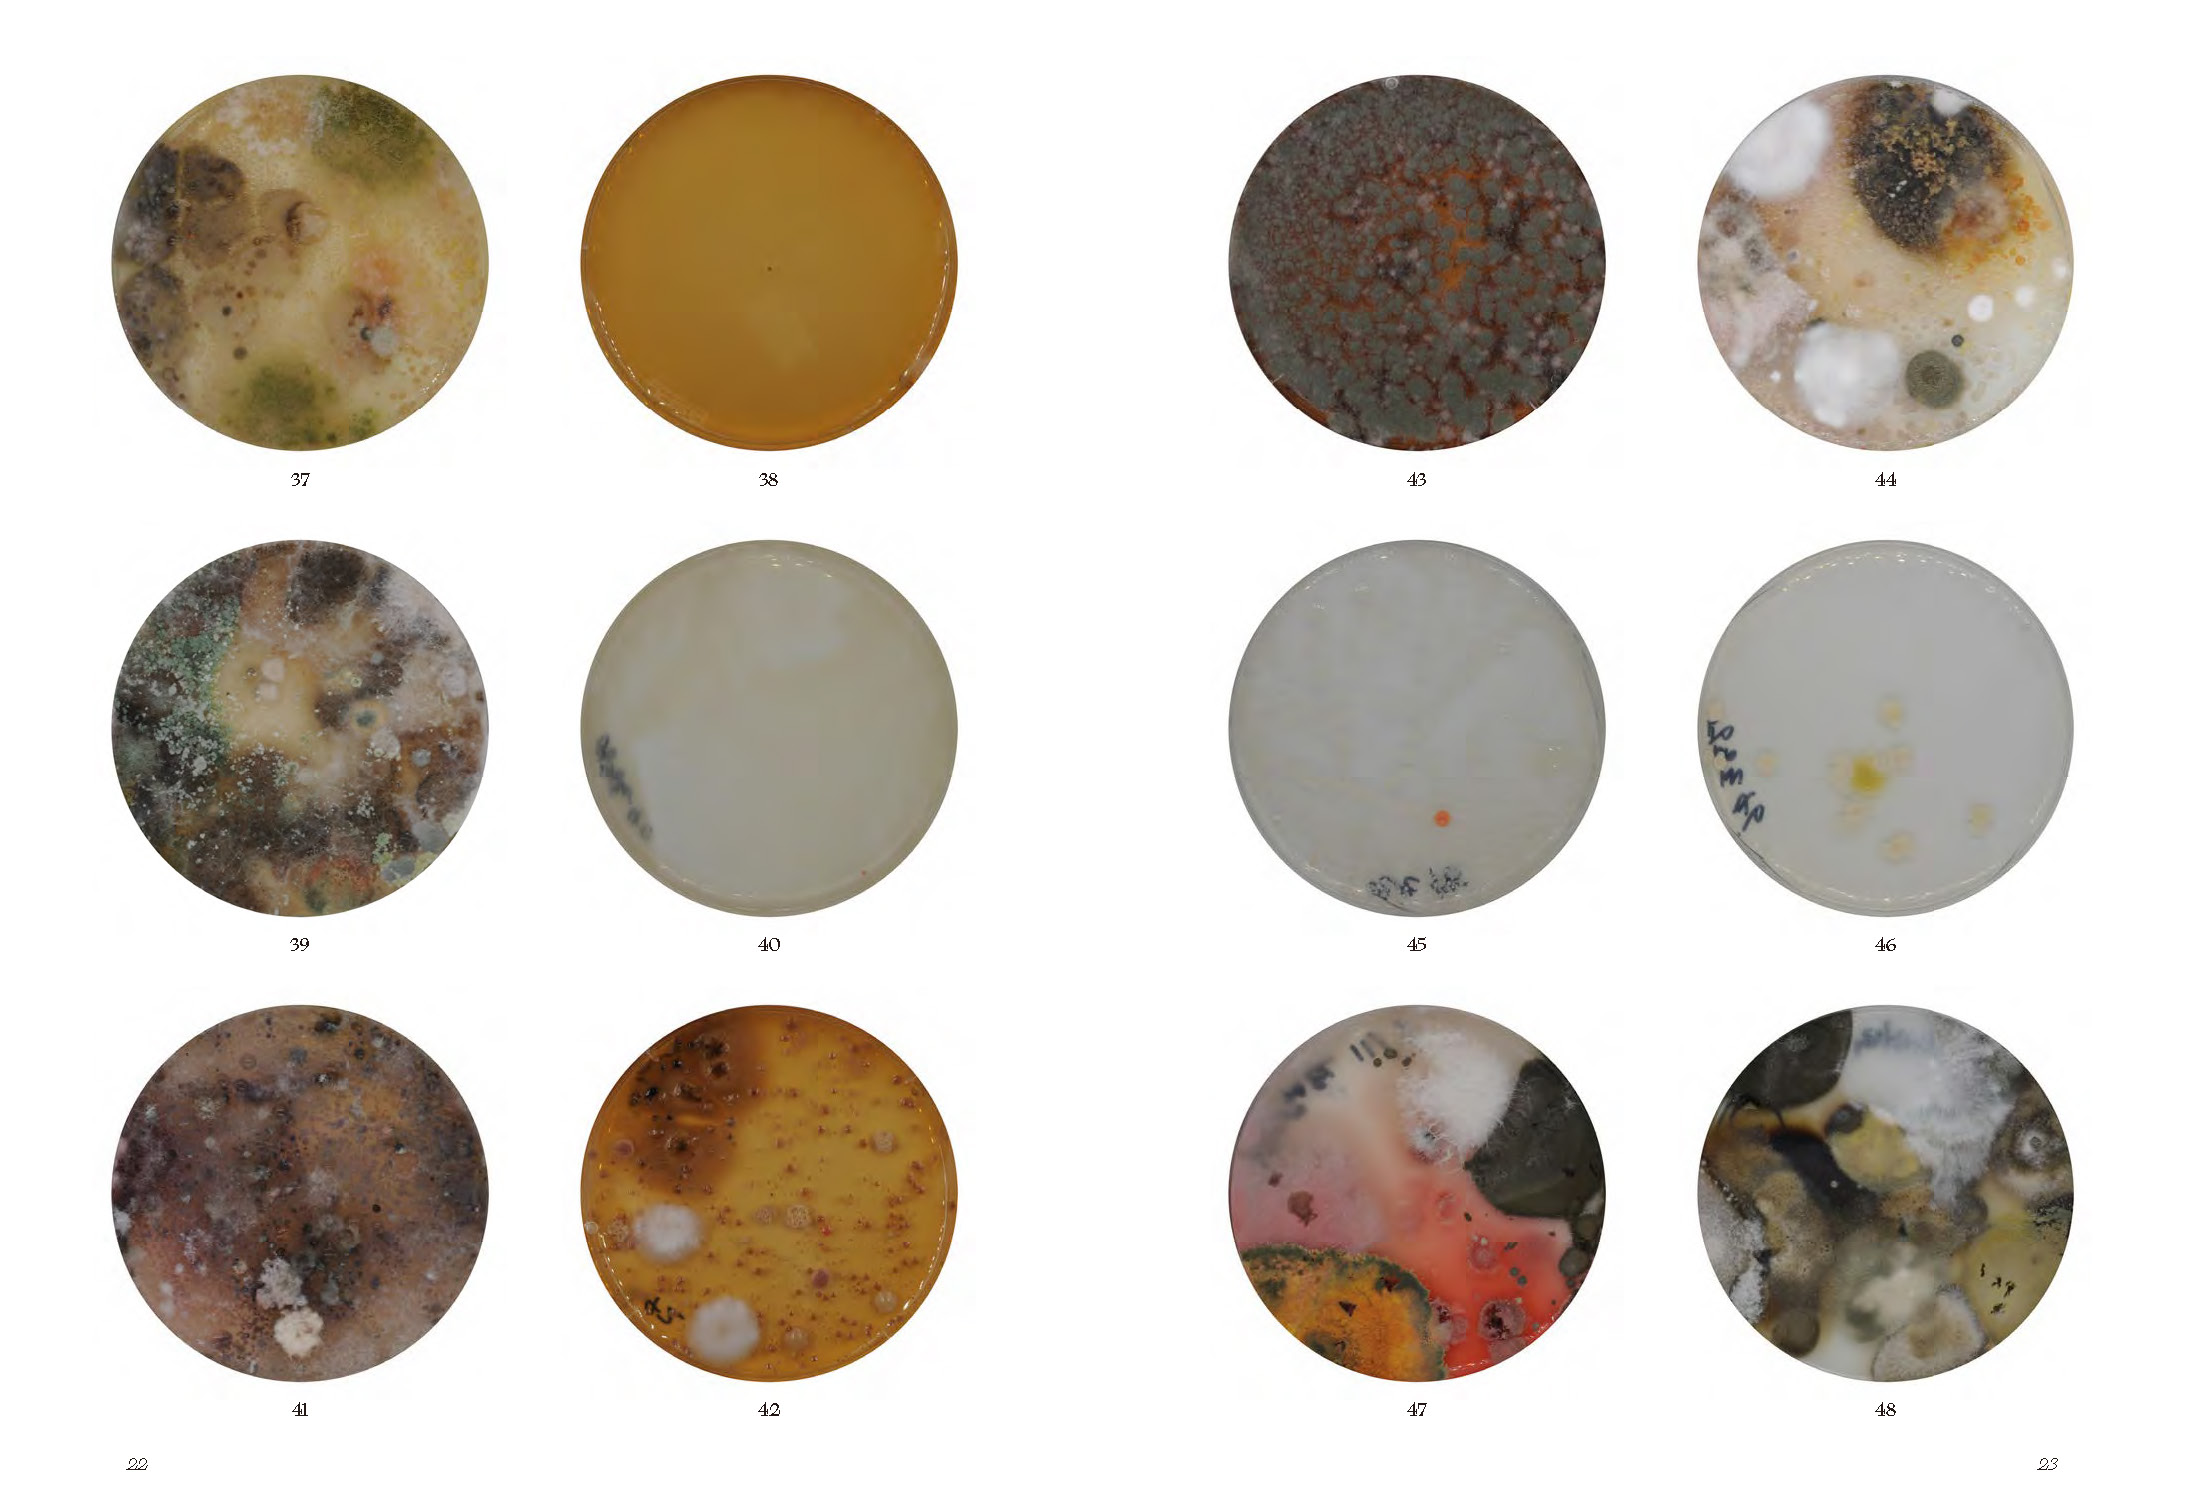
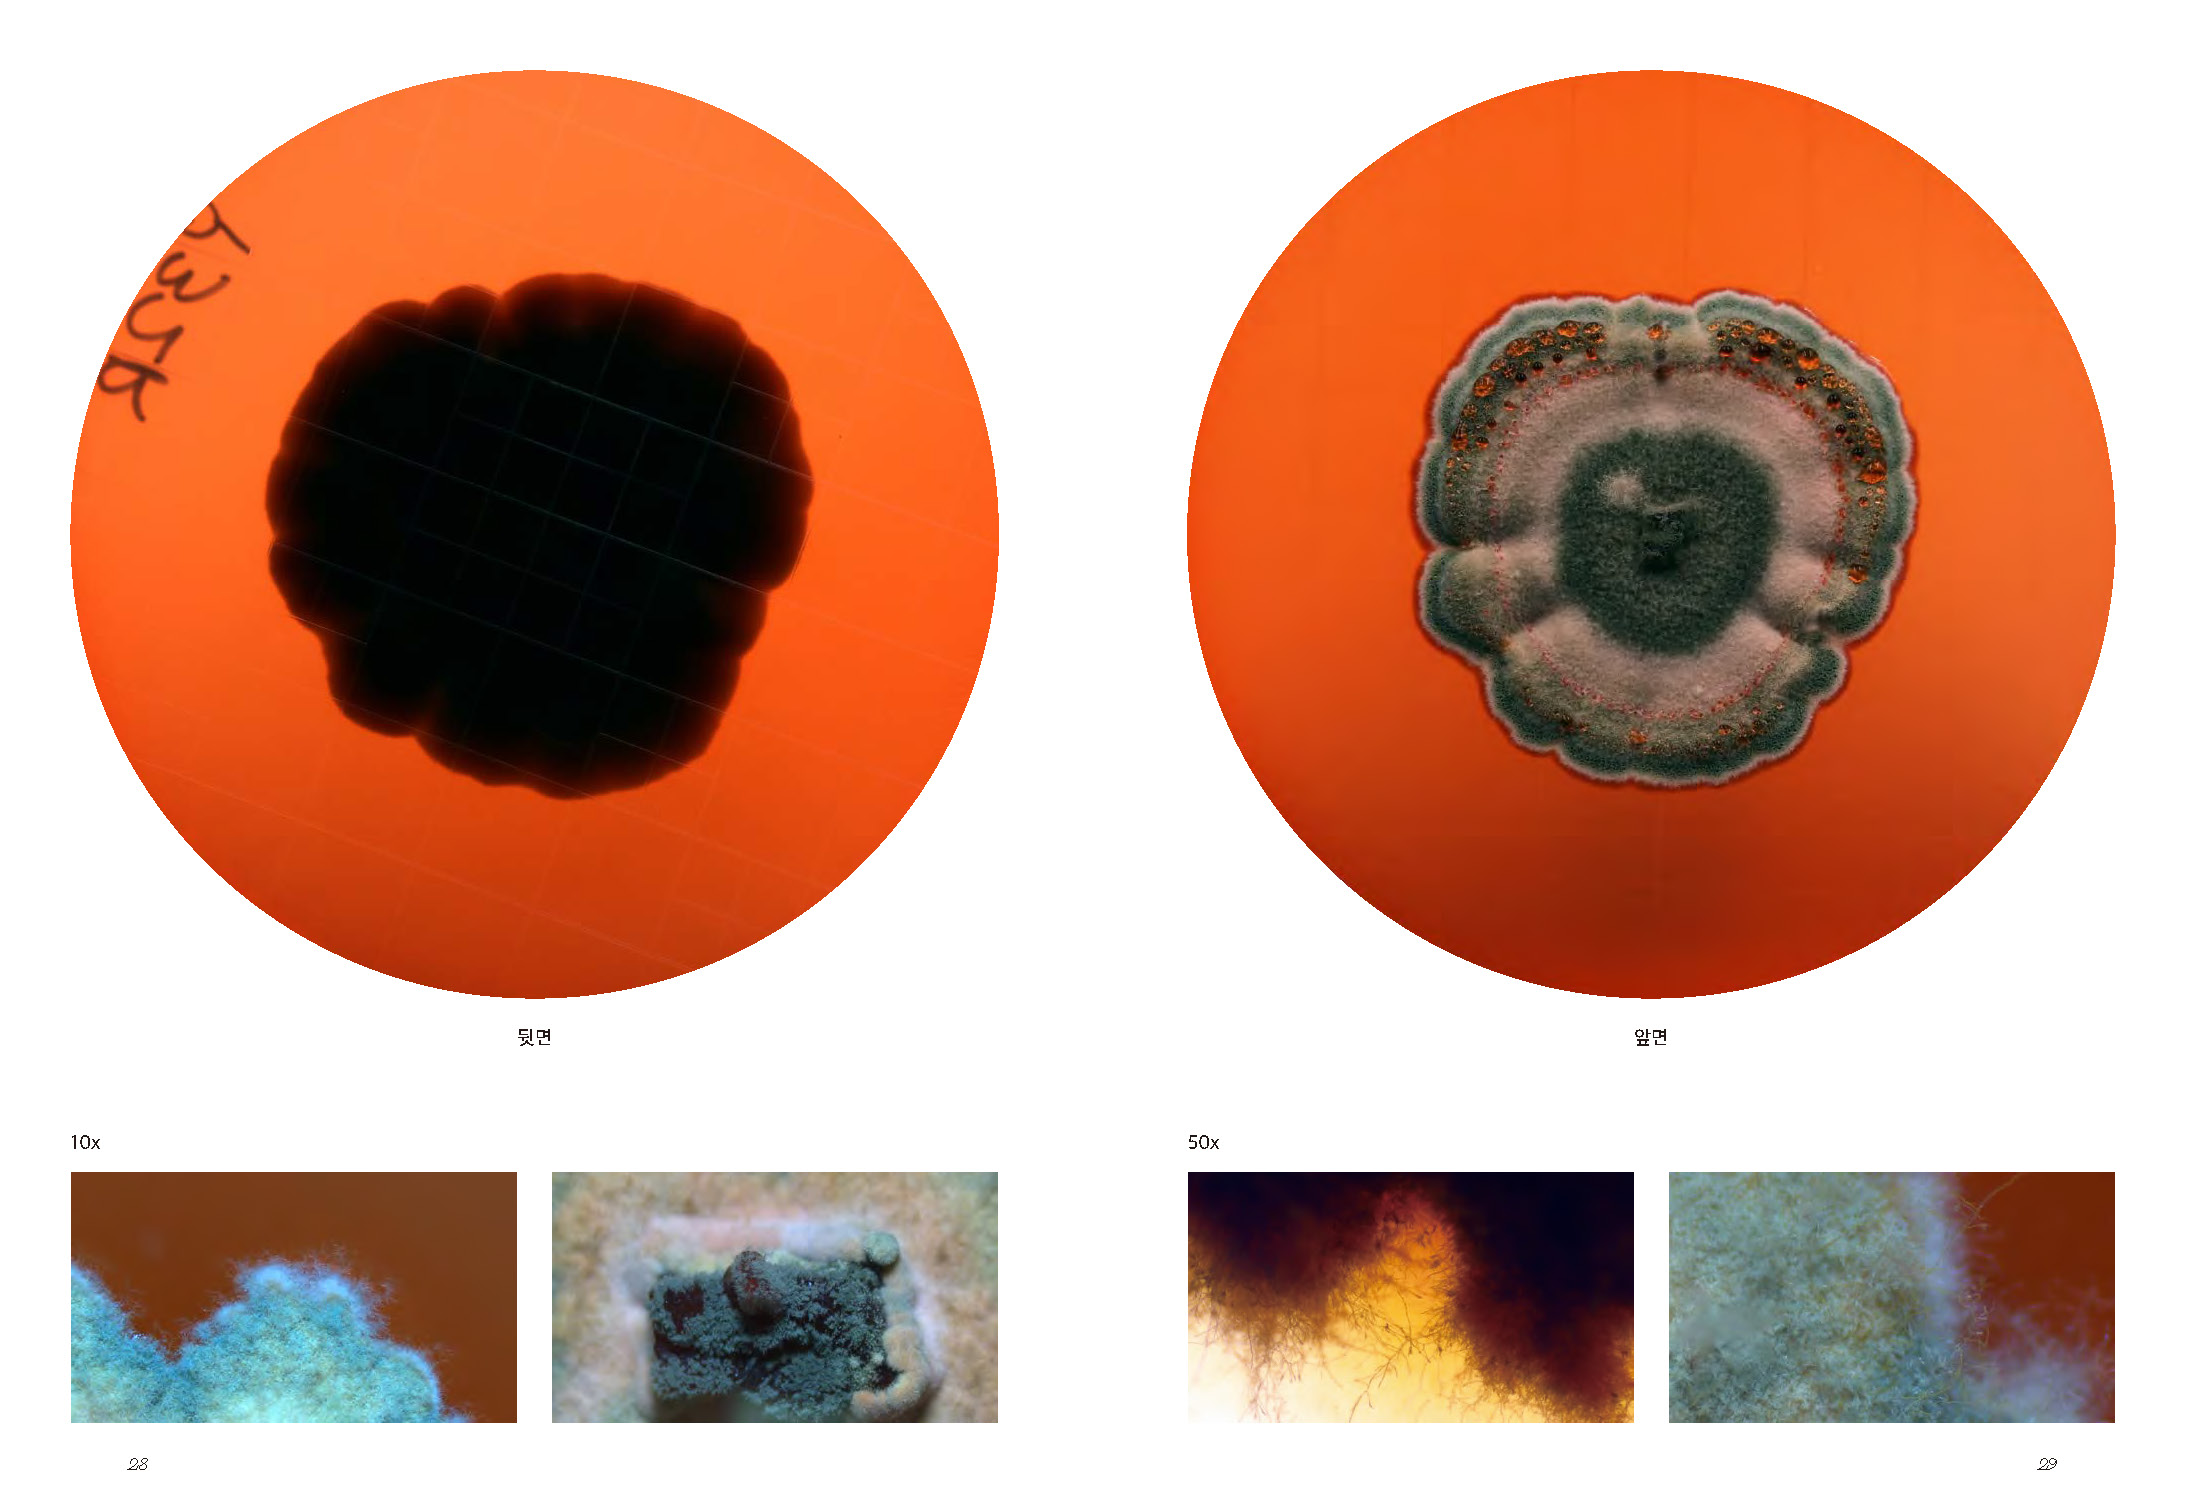

Former Kyungsung Textile Office building, 2022
︎
Elliptical Orbit 1. is part of the project Drawing Elliptical Orbit, which has been in progress since 2020, collecting surface dust from the former Kyungsung Textile building in Yeongdeungpo, Seoul, and growing mold in it to find colour in 2022. This is part of the work created to trace the history of the regenerated former Kyungsung office building.
The regenerated industrial architecture is the result of an effort to evoke a common memory by eliminating many parts due to the complicated historical and political context of the past. And a myriad of parts left out in the process are scattered everywhere like spores, unnoticed by the naked eye. Nevertheless, this elliptical part is carried out on the premise that as long as we perceive that it has been omitted, and as long as there is a spore that we remember, and as long as the part that is considered not to be there ever lives up to the condition, this existence can be brought to light at any time. Indeed, until they are brought forward, we are clueless as to whether such exposed things are those to which we have all tacitly consented or not, or even whether they are other things that exert influence to the extent of turning the whole proposition upside down.
︎
Stop movement-entrance, steel frame, conveyor, resin with mold pigment, variable dimensions, 2022





︎
Spiral movement, mold pigment dyed knitting, variable dimension, 2022
Spiral movement, mold pigment dyed knitting, variable dimension, 2022


︎
Drawing (Kyungsung textile office building), resin with mold pigment, 6 types of collected mold, variable dimensions, 2022
Drawing (Kyungsung textile office building), resin with mold pigment, 6 types of collected mold, variable dimensions, 2022

︎
Untitled, mold pigment dyed sliver dust with color test chart, variable dimensions, 2022




︎
Orbit 1. | documentation book

︎
Elliptical Orbit | exhibition recording video
Youtube Link ▸▸▸